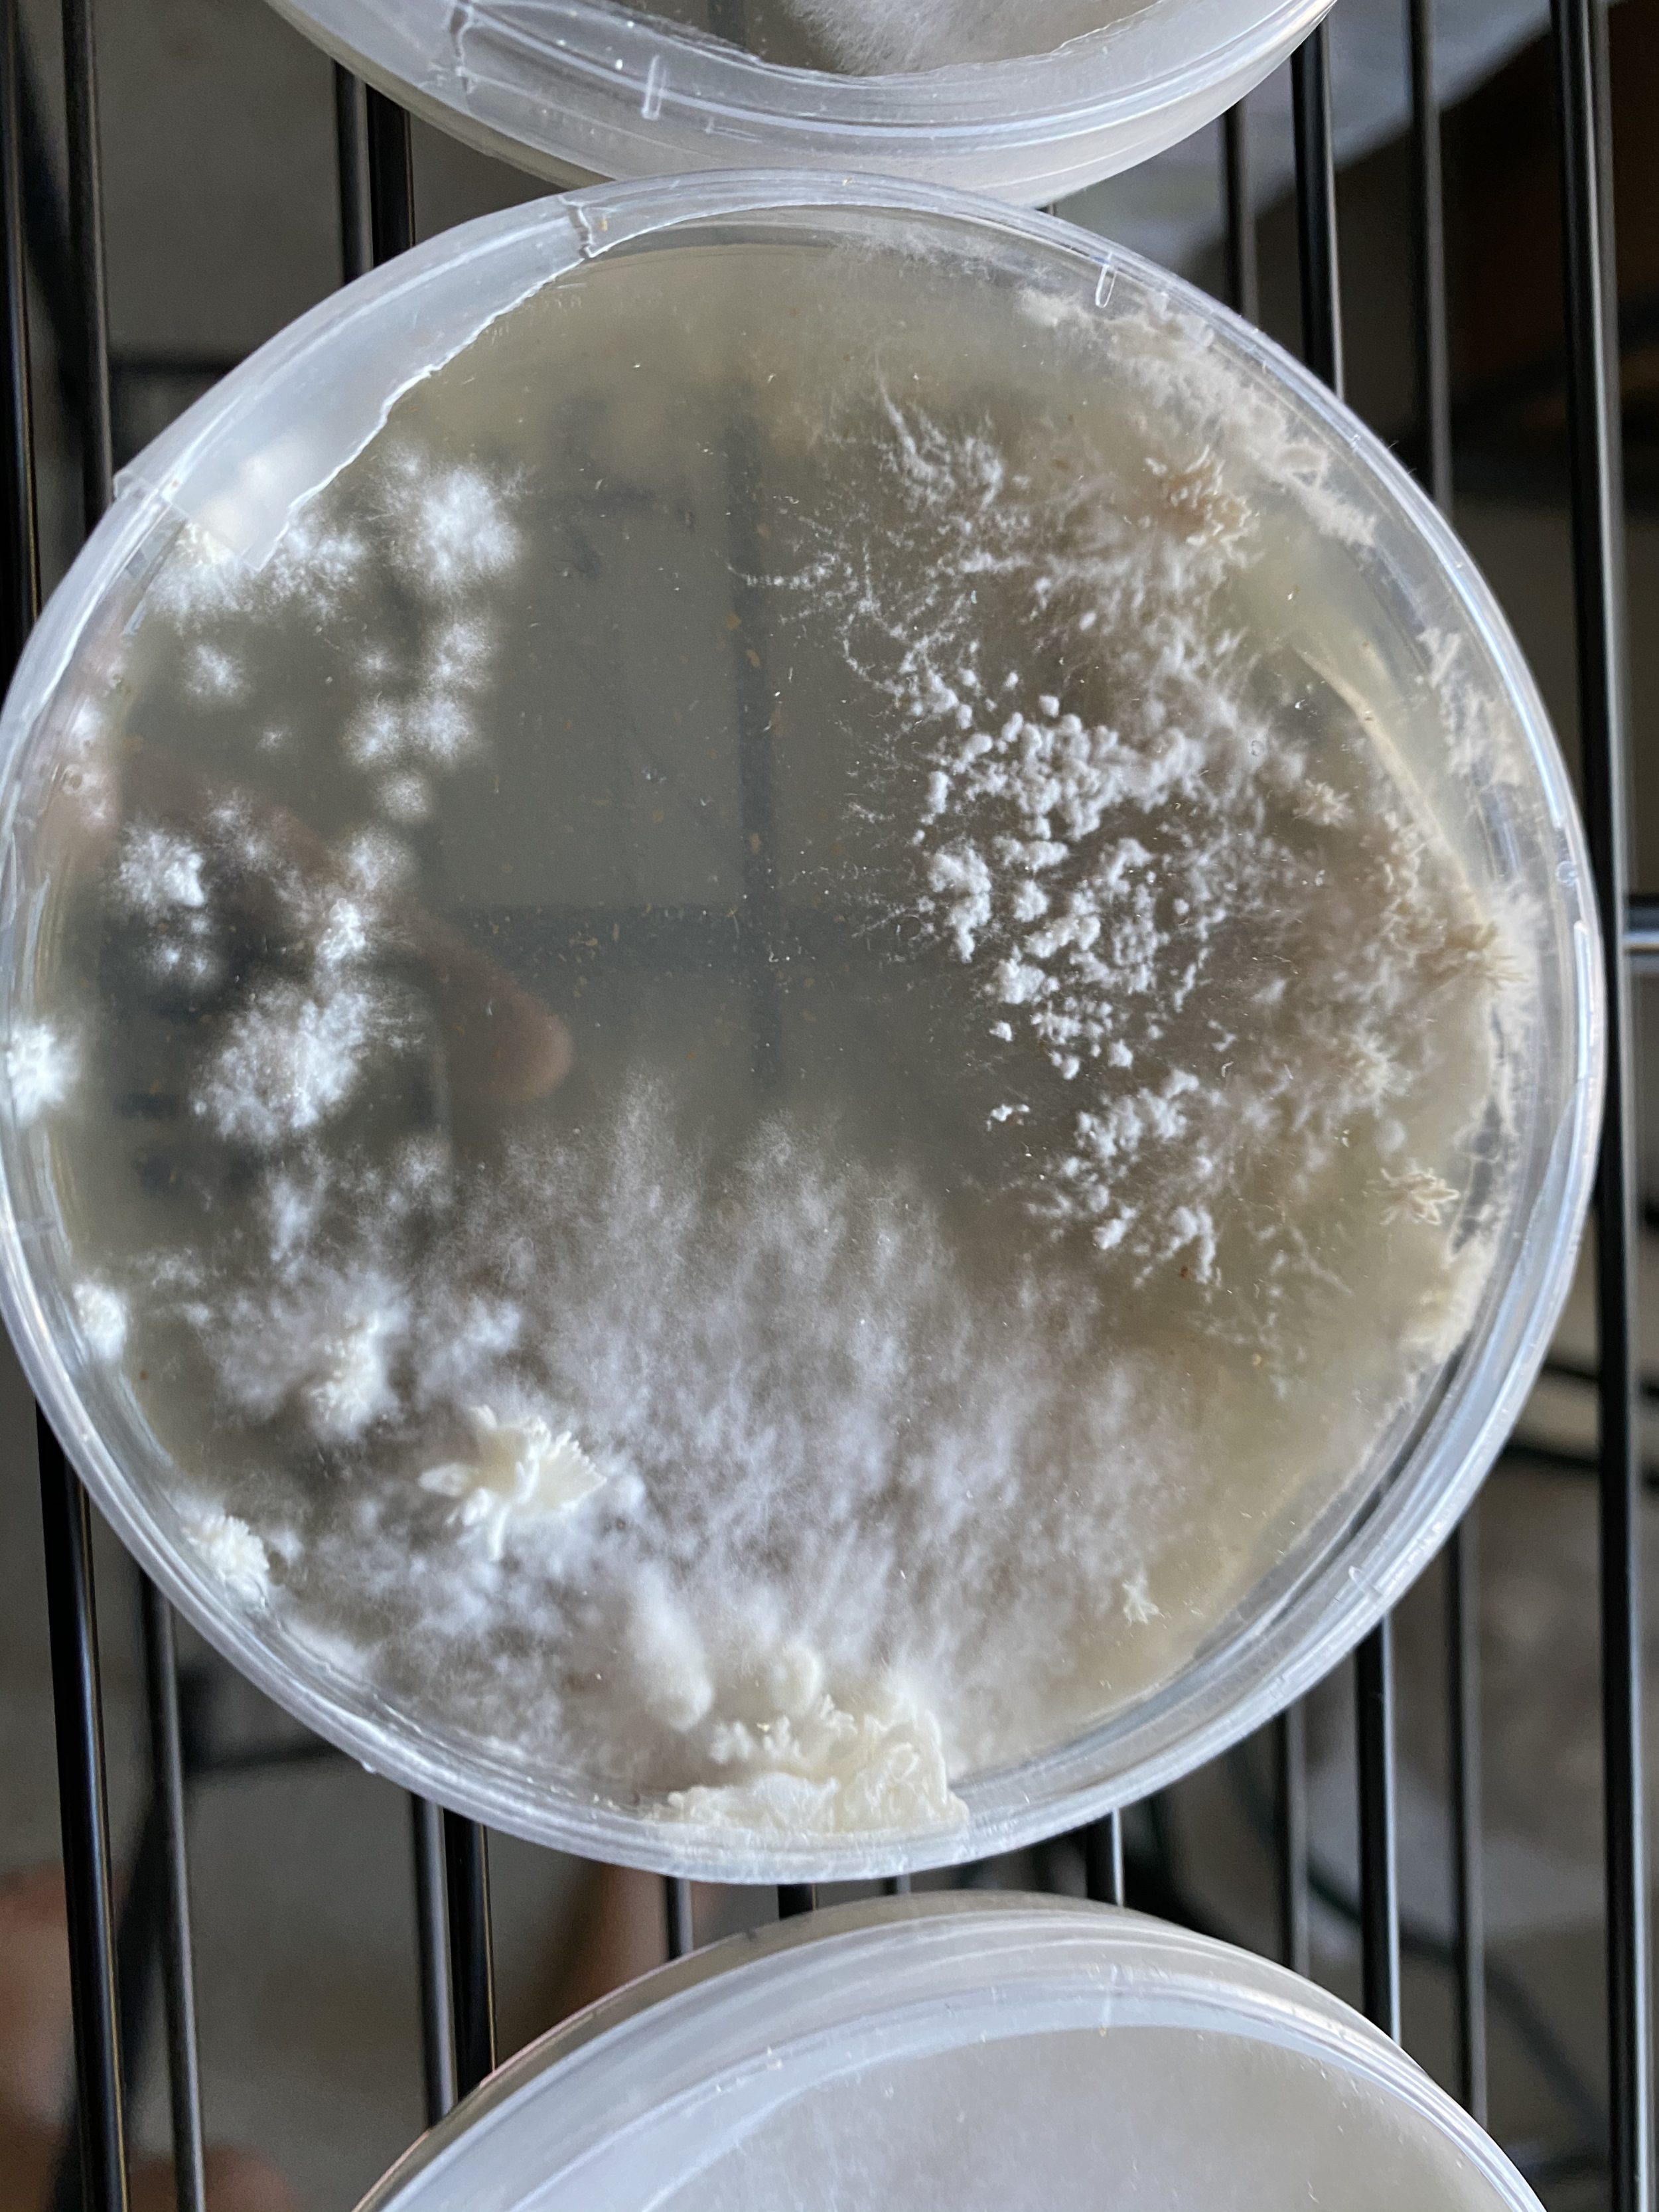
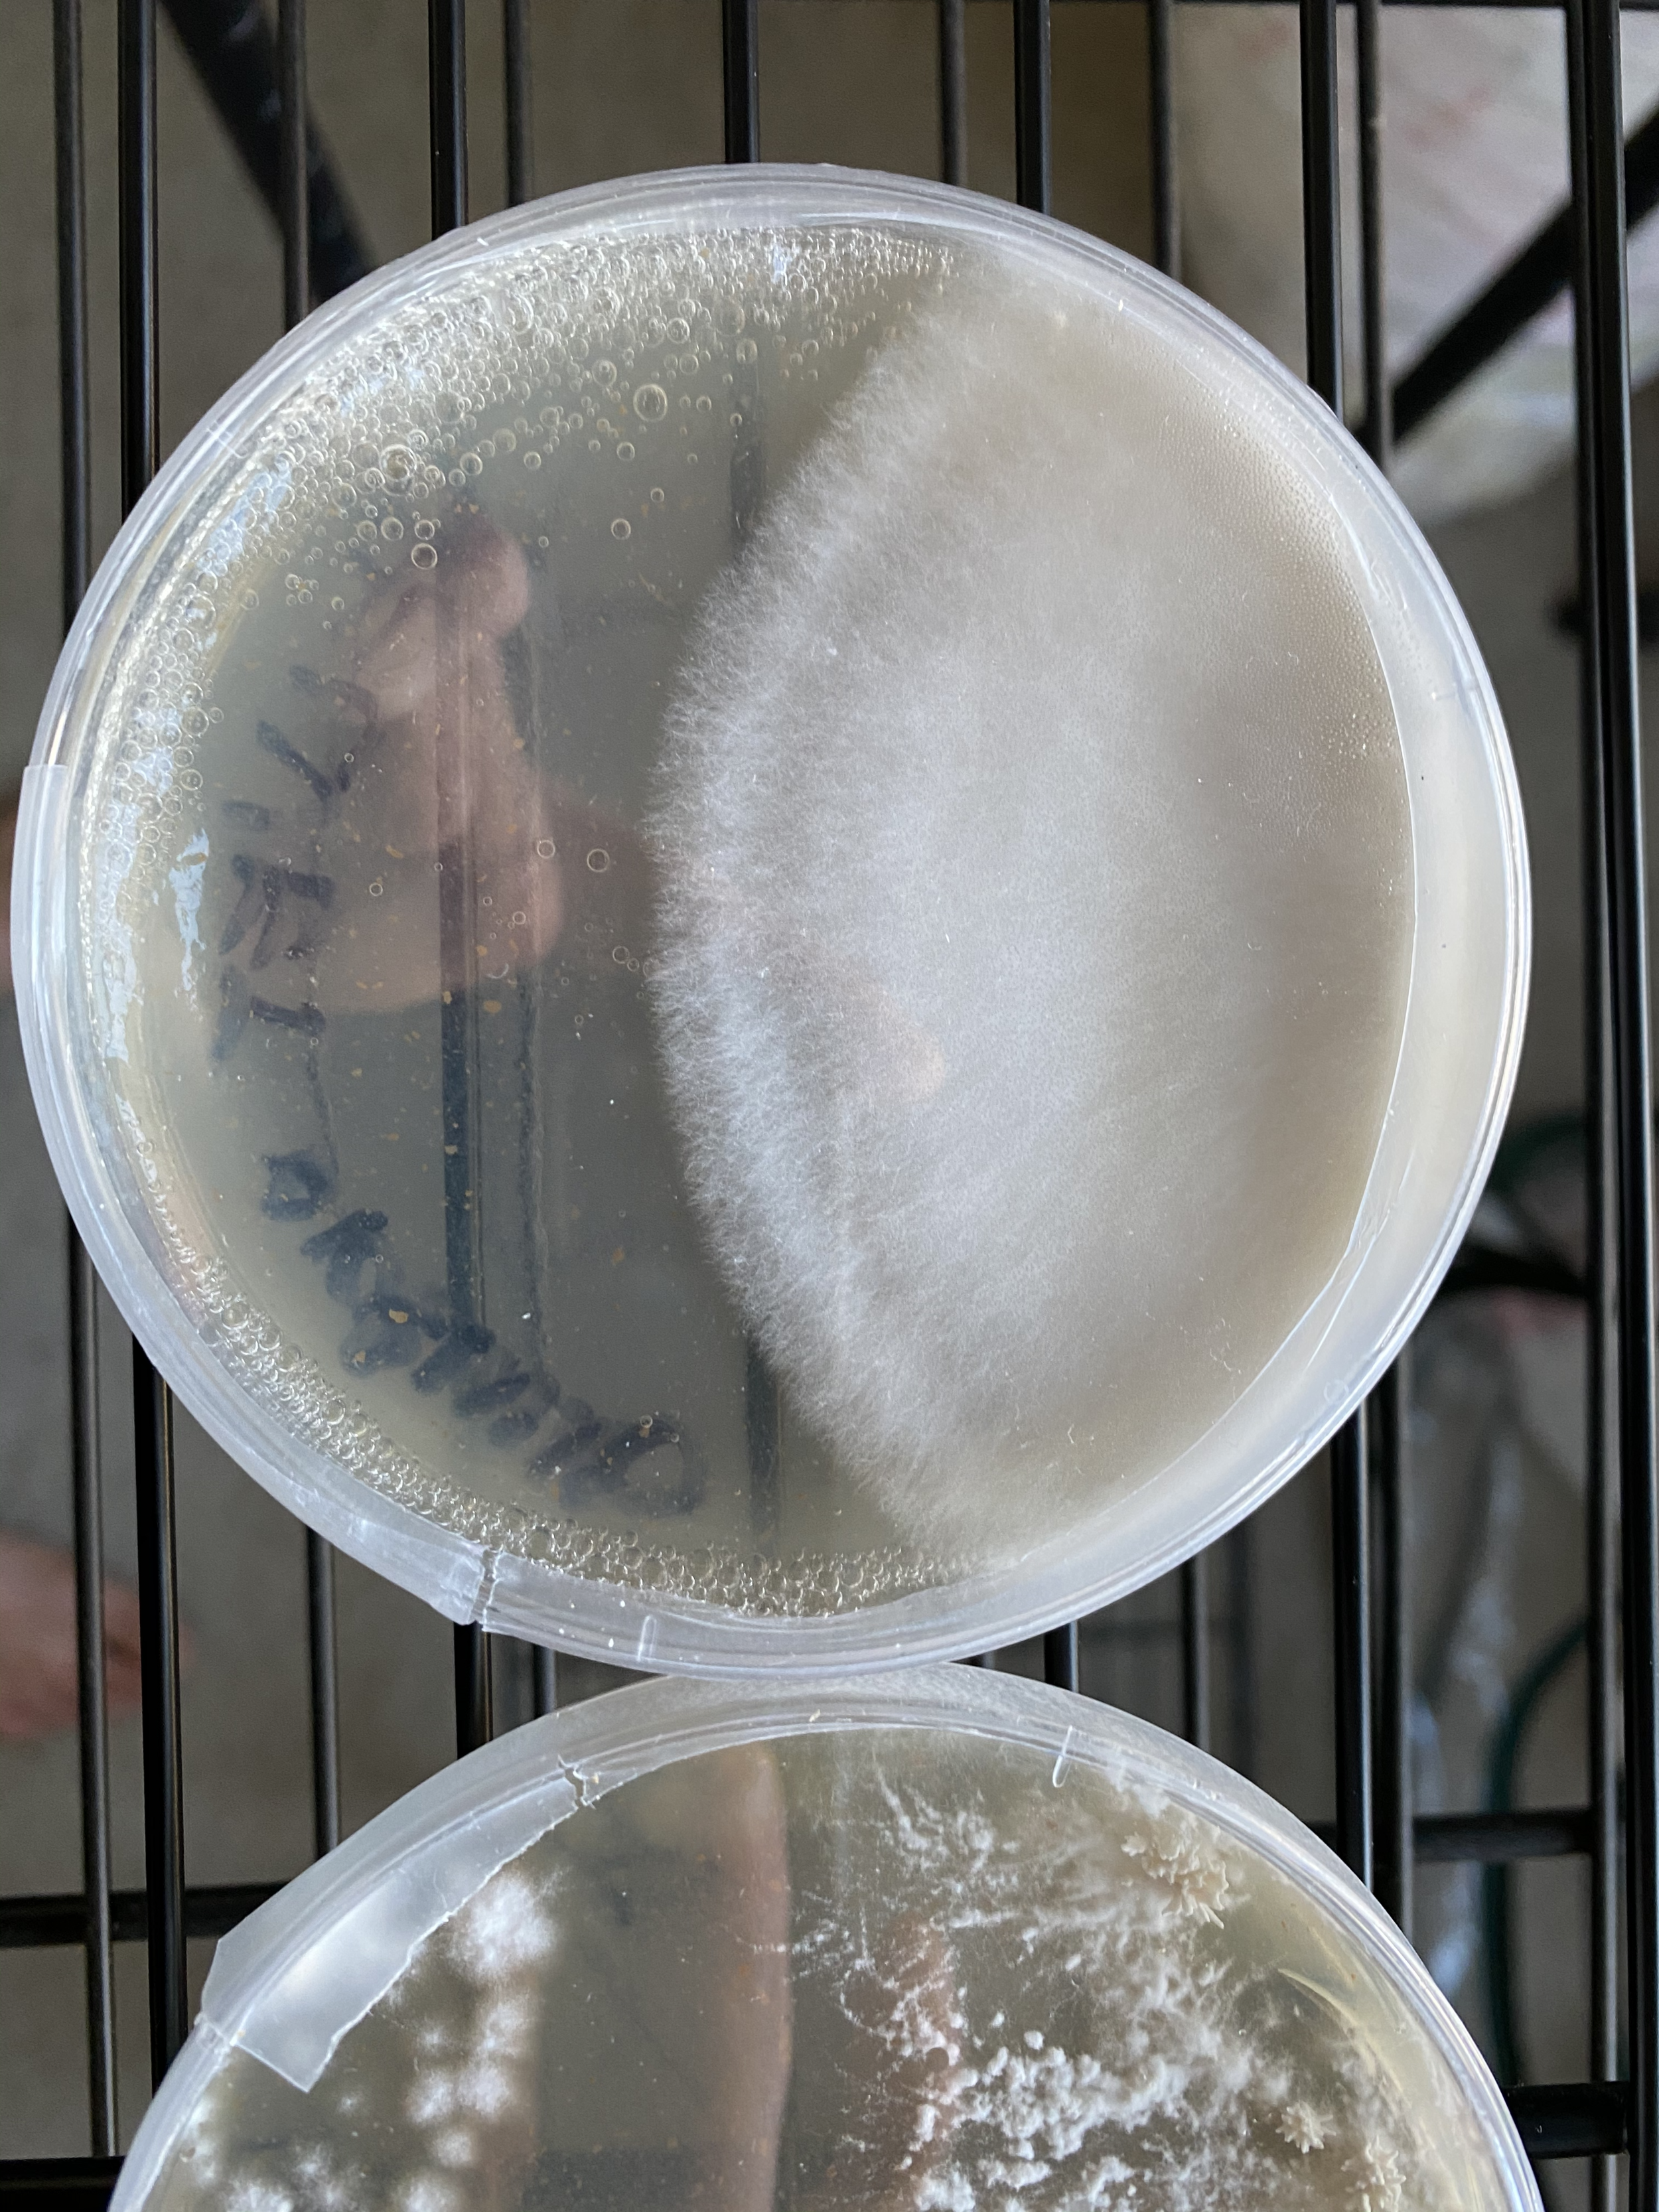

shroombaby part II (20q4)
shack building in full swing
We are 85% done and could not be more excited. Here is our remaining task list:
Finish laying tile
Wrap up solar roofing placement
Install a drain, chamber lighting and racks
Setup control room
if you want to blow a project’s scope: give us a call
Our build is intense… but in addition to automation and energy-saving initiatives, we added many custom features along the way. And so far we all have our priorities: aesthetics for mom, costs for dad, functionality for me. The fun part has been striking a balance :-).
It’s getting cold, but one thing we can all agree on: it is much easier to work in the cold in the central valley than it is in the heat — the summers can be unbearable.
in case anyone wants some laughs, this is what a day working with us is like
aka possibly Mom and Dad giving you mixed instructions
in progress: DIY cultivation
In parallel we are learning, developing, and optimizing our cultivation strategies. Our simplified process includes:
scale zero, initiating
Ordering mycelium syringes | taking samples from existing organisms
Preparing and sterilizing agar agar
Inoculating agar agar with our fungus via sterile injection or fresh tissue sample
scale one, liquid culture
Preparing and sterilizing liquid culture broth
Inoculating liquid culture broth with our fungus via sterile injection and incubating mixture
scale two, grain spawn
Preparing and sterilizing rye berries
Inoculating rye berries with our fungus via sterile injection and incubating mixture
scale three, fruiting substrate
Preparing and sterilizing final fruiting substrates
Inoculating final fruiting substrates with our fungus via sterile injection and incubating mixture
Initiate pinning, wait x time, harvest!
Preparation, Practice and Patience and the right tools are required in any biological operation.
the mixing process, let me tell you…
I stick to two fruiting recipes: masters mix and sawdust / wheat bran. Mushrooms (and mycelium) require a few organic elements to survive— very similar to us, in fact they exhale CO2 and inhale O2! Basically they need:
carbon (sawdust) for energy
nitrogen (wheat bran) to make proteins
oxygen (+ other molecules) to breathe
minerals (gypsum)
water to grow
Some of the more complex requirements for actually growing a mushroom are:
high volume air-exchange
light control
temperature control
I mix all the ingredients by weight or volume depending on the recipe (highly exhausting— ask for help), bag them up, pressure cook for three hours outside, then unload them in front of my hood on elevated blocks.
the Airport Lid
This was the contribution to mycological research from Radical Mycology, invented by Peter McCoy. You apply high-temperature silicon to the lid and create a gasket that allows you to enter in and out of the jar via a needle maintaining sterility. It’s a brilliant and cost effect method, however we found the red gaskets weren’t sturdy and we would spend lots of time repeating this process. In addition, in our case we discovered these lids weren’t reusable.
We are currently using a combination of pre-made injection ports and 3M micropore tape.
We really like this combination right now!
Almond-mycelial-band revival
This was a personal pet project of mine. One of the vendors I work with to purchase strains from said this particular one could not be refrigerated as it will die and will no longer be viable.
Well, I put that to the test. Busy with other projects, I left this one in this fridge for about 10 months, give or take. And yes… it definitely appeared dead. It had a brown, rotted, decrepit look to it and resembled brown dust more than a living organism. challenge accepted— I was determined to revive it back to life.
Every morning, first thing, I would go gently and diligently shake the jar to oxygenate it— unfortunately this one didn’t have a stir bar. At night, I would repeat. After about three weeks, I could see fresh hyphae forming at the ending of the gross dead thing. Was I dreaming??!! Was it working?! Are they really that resilient?! My parents confirmed the growth.
This went on for oh, maybe… 4 months? Completely elated, I took it into the grain spawn phase. It myceliated slowly but beautifully— we reached full myceliation around the eight week mark.
Unfortunately I did not get a chance to fruit this one, but not bad considering the circumstances! This guy was robust and came back to life to say hi to us :-) I saved a clone.